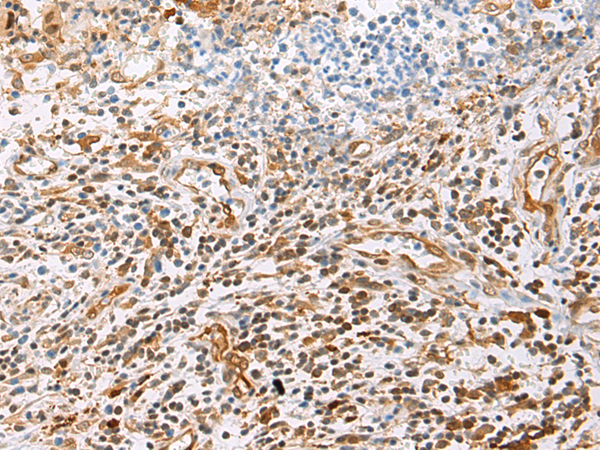

相關類別: 一抗
宿 主: Mouse
|
Background: |
This gene encodes a member of the peroxiredoxin family of antioxidant enzymes, which reduce hydrogen peroxide and alkyl hydroperoxides. The encoded protein may play an antioxidant protective role in cells, and may contribute to the antiviral activity of CD8(+) T-cells. This protein may have a proliferative effect and play a role in cancer development or progression. Four transcript variants encoding the same protein have been identified for this gene. |
|
Applications: |
WB, IHC |
|
Name of antibody: |
PRDX1 |
|
Immunogen: |
Fusion protein of human PRDX1 |
|
Full name: |
peroxiredoxin 1 |
|
Synonyms: |
PAG; PAGA; PAGB; PRX1; PRXI; MSP23; NKEFA; TDPX2; NKEF-A |
|
SwissProt: |
Q06830 |
|
IHC positive control: |
Human prostate cancer and Human tonsil; Human esophagus cancer and Human colorectal cancer |
|
IHC Recommend dilution: |
100-500 |
|
WB Predicted band size: |
22 kDa |
|
WB Positive control: |
NIH/3T3, HepG2, Hela, K562 cell, Mouse brain tissue, Mouse liver tissue, PC-3 cell lysates |
|
WB Recommended dilution: |
1000-5000 |

購物車
幫助
021-54845833/15800441009
